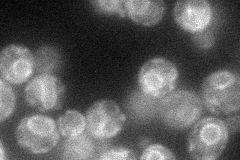
YPL189W
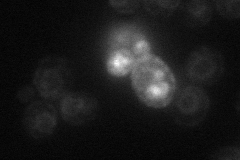
YPL189W
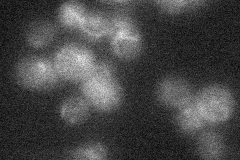
YPL189W
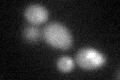
YPL189W

View description
Probable membrane protein with a possible role in proton symport of glycerol; member of the MBOAT family of putative membrane-bound O-acyltransferases; Gup1p homolog
Localization:
Intensity:
Fold change:
Significance:
-
C’ GFP library in SD

below threshold19.07 -
N' NOP1pr-GFP in SD
ER46.2378 -
N' TEF2pr-mCherry in SD
ER15.6463 -
N' NATIVEpr-GFP in SD
below threshold13.4447 -
N' TEF2pr-VC and Cyto-VN in SD

#N/A0 -
C’ GFP library in SD+DTT
cytosol19.481.02No -
C’ GFP library in SD+H2O2

cytosol17.580.92No -
C’ GFP library in Starvation Media

cytosol17.910.93No -
C’ GFP library on the background of Pup2-DaMP

below threshold -
C’ GFP library on the background of CCT mutant

below threshold16.60930.870578No
